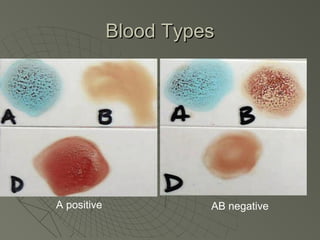
Blood Types




A positive             AB negative

The document discusses the clinical/anatomical laboratory profession. It notes that 70-80% of medical decisions are based on laboratory test results and that modern medicine relies heavily on laboratory tests. It describes various laboratory professional roles like medical technologists, technicians, and pathologists' assistants. It also outlines the different areas of study within clinical and anatomical pathology laboratories like microbiology, hematology, chemistry, and provides examples of common laboratory tests and procedures.